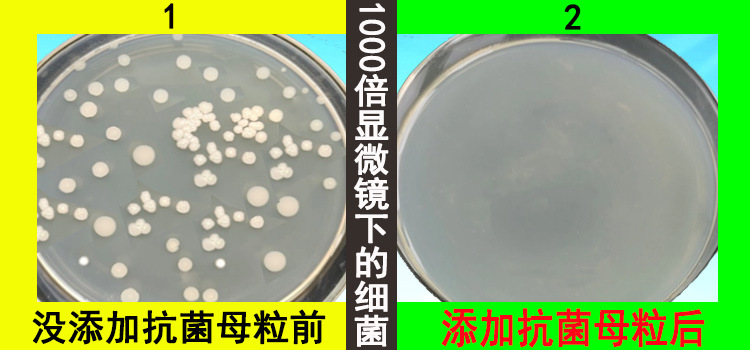
抗菌對比圖1

|
抗菌母粒 |
塑料防霉母粒 |
流紋色母粒 |
|
PP抗菌色母粒 |
抗菌防霉母粒 |
抗靜電母粒 |
|
塑料抗菌母粒 |
PP無紡布抗菌母粒 |
鐳雕母粒 |













金塑顏公司于 2014 年在東莞成立,是一家專注于研發(fā)和制造的企業(yè)。公司
主要產(chǎn)品涵蓋:抗菌母粒、紅外線穿透塑膠、香水外殼專用 ABS 料、荷葉效果
不沾水的 PP 料、塑料改性定制、各類色母粒、絕緣色母、流紋色母、化妝品顏
料等。公司不僅榮獲了自有商標及發(fā)明專利,其工廠還通過了 ISO 認證,產(chǎn)品
具備各種檢測報告。
公司始終秉持不斷創(chuàng)新的理念,能夠及時有效地解決客戶的需求并提供專業(yè)
的解決方案,由此贏得了廣大客戶的長期支持與信任。公司產(chǎn)品遠銷海外及全國
各地,歡迎各界朋友前來咨詢和指導。
服務(wù)熱線:0769-22204898
聯(lián) 系 人:李先生/153-6282-2225
Q Q:910736411
網(wǎng) 址:www.kkimqi.cn/
掃一掃 手機站二維碼
掃一掃 微信公眾號
掃一掃 微信小程序
在線咨詢服務(wù)熱線
聯(lián)系電話
關(guān)注微信

手機app

小程序

微信公眾號
